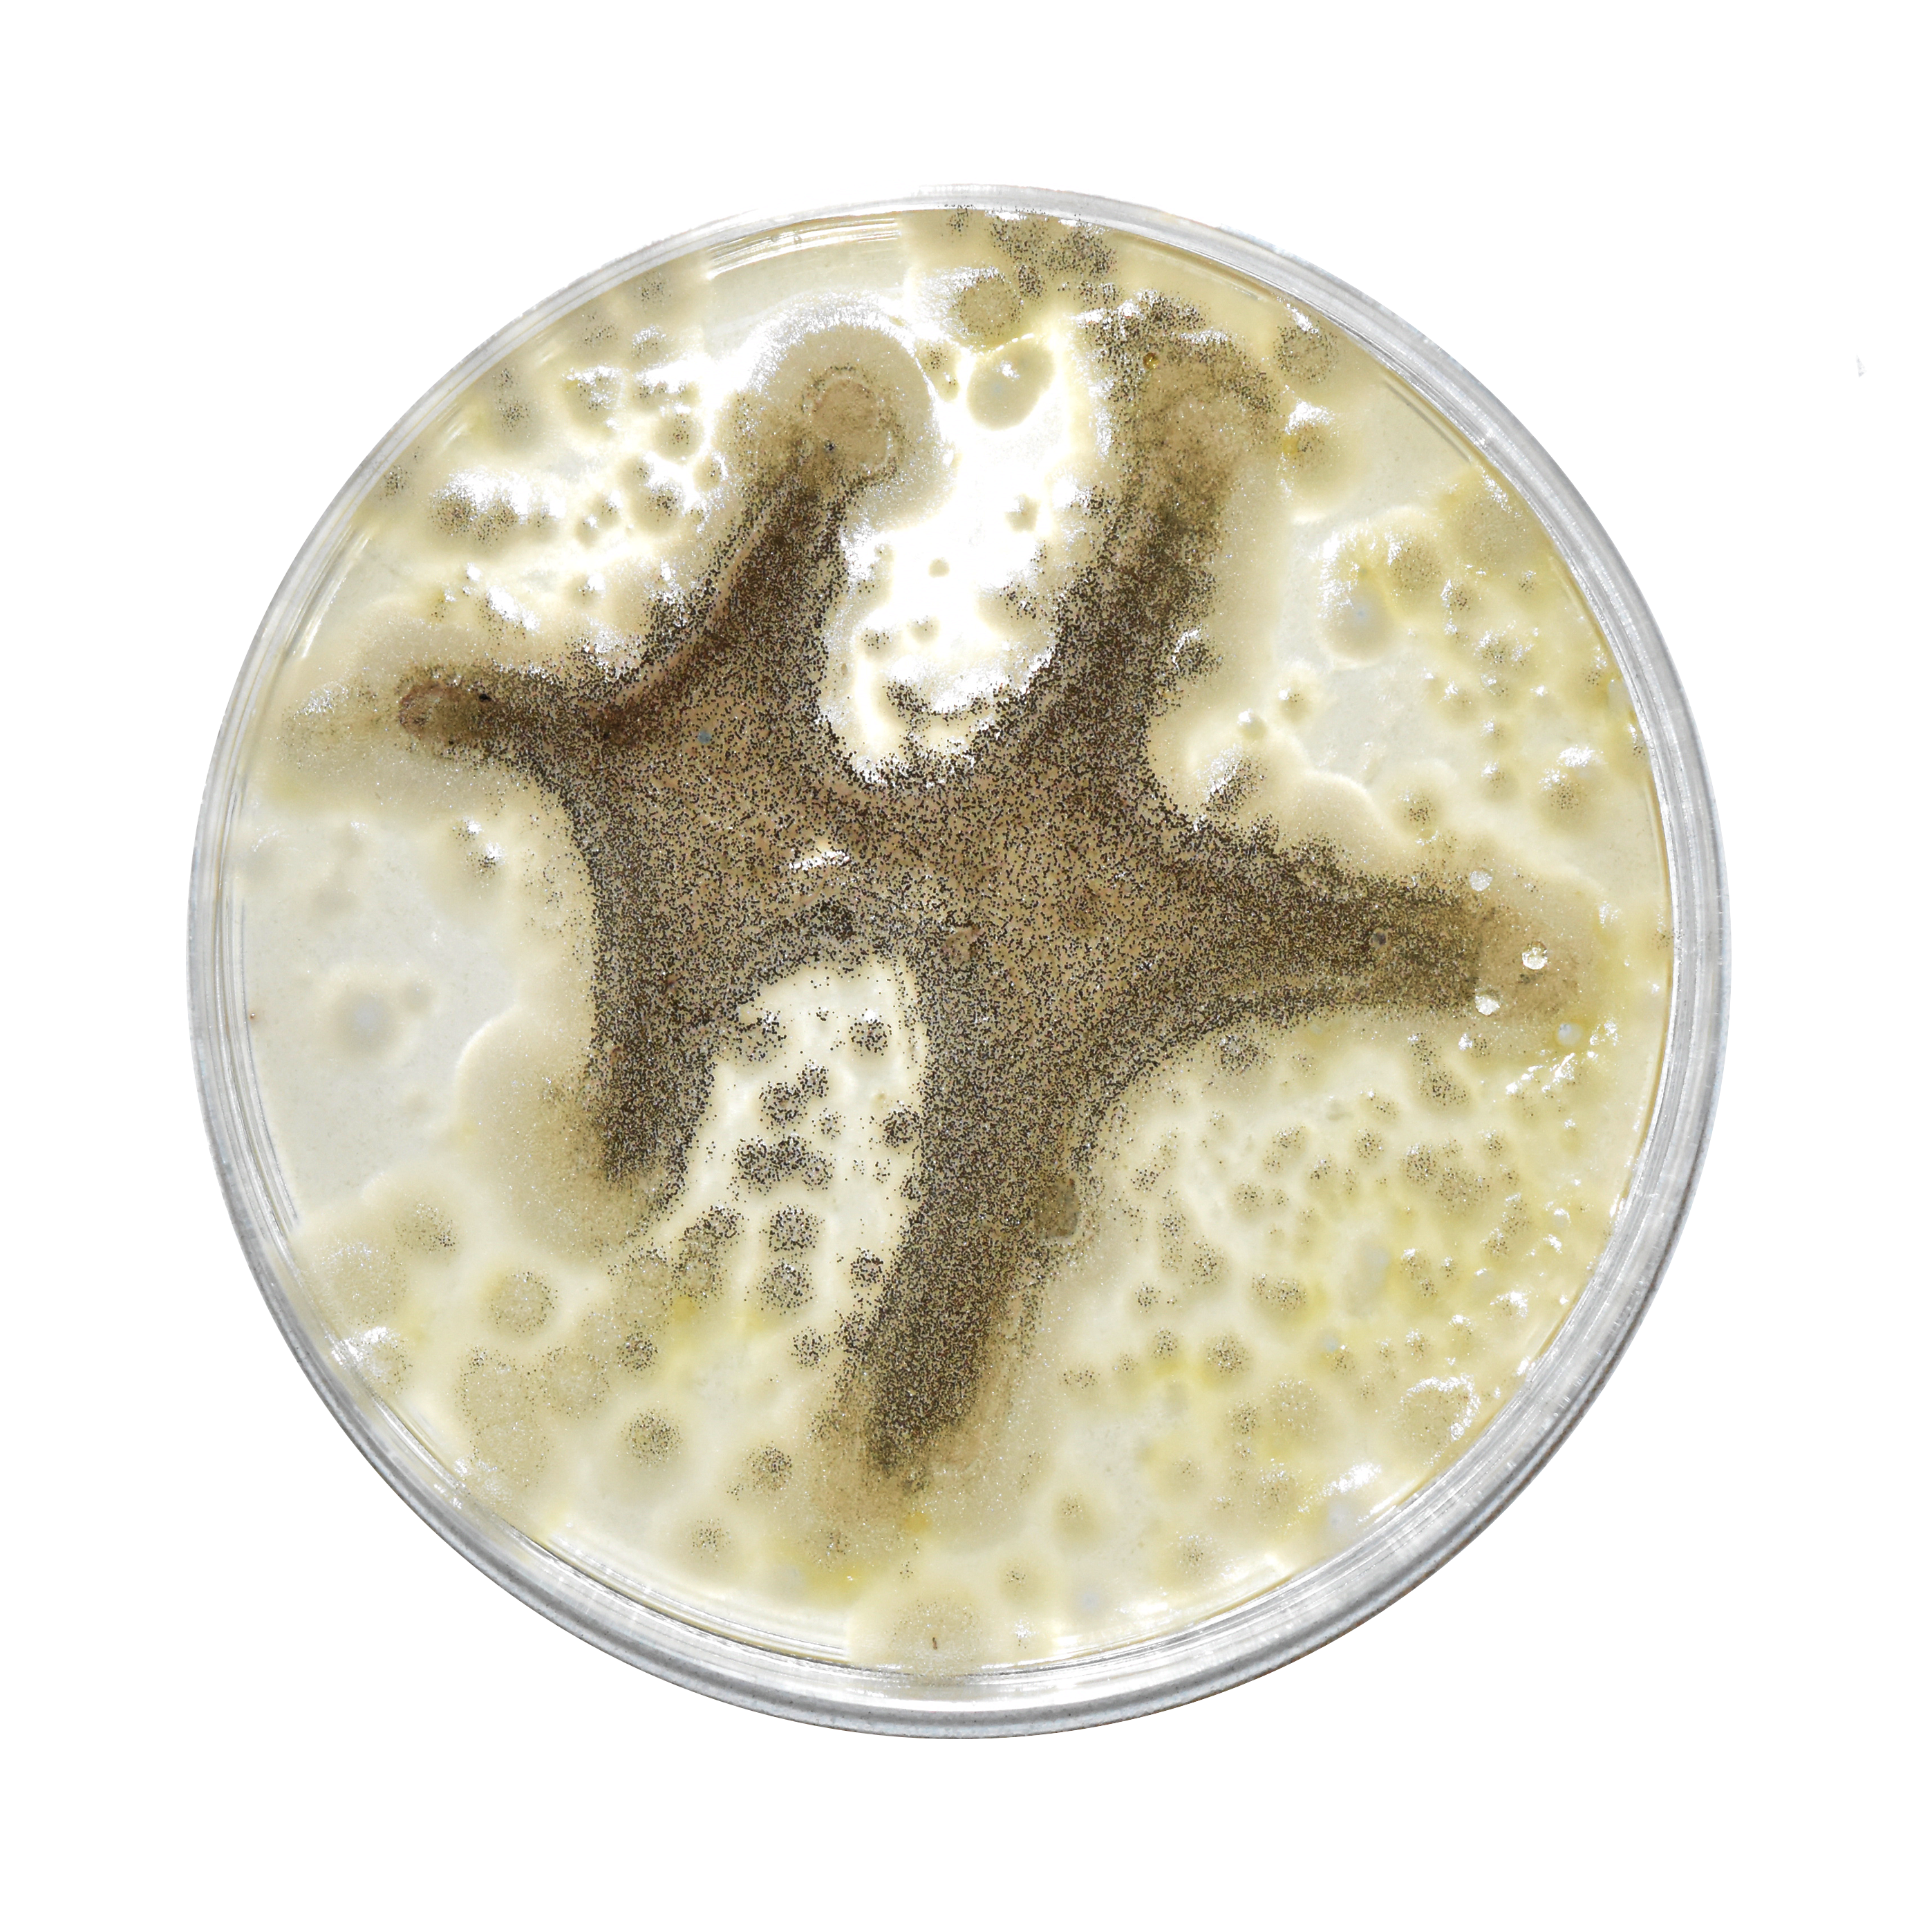

ruby red
2023
artist site
Using live camera feed, rubyred.world randomly populates your 3d space with music, merch, and maybe even unreleased music –– no two “galleries” are the same.
the context in which listeners discover new music is often overlooked. by using augmented reality to contextualize ruby red within new spaces, that moment of discovery becomes enhanced and personalized.
web design + development